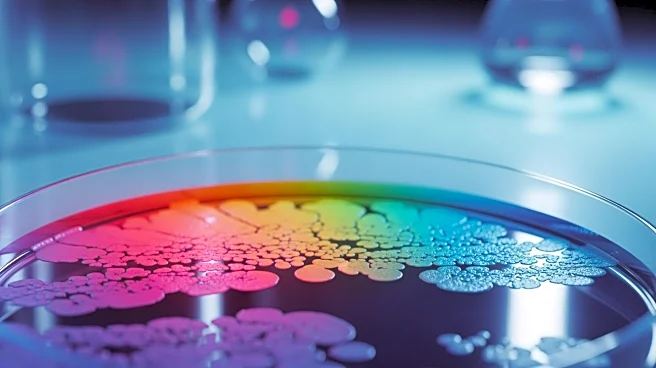
Study Reveals Modern Diets Drive Rapid Evolution in Gut Bacteria

What's Happening?
The historic Queen Mary ship is set to host a Masquerade Soirée on New Year's Eve, offering guests a unique and festive way to ring in the new year. The event promises an evening of elegance and entertainment aboard the iconic vessel, which is docked in Long Beach, California. Attendees can expect a night filled with music, dancing, and themed activities, all set against the backdrop of the ship's storied history and grandeur.
Why It's Important?
The Queen Mary's New Year's Eve event highlights the ship's ongoing role as a cultural and entertainment venue, drawing visitors from across the region. This celebration not only provides a memorable experience for attendees but also supports local tourism and the preservation of the historic ship. Events like these contribute
to the cultural vibrancy of the area and offer a unique alternative to traditional New Year's celebrations, potentially attracting a diverse audience seeking novel experiences.